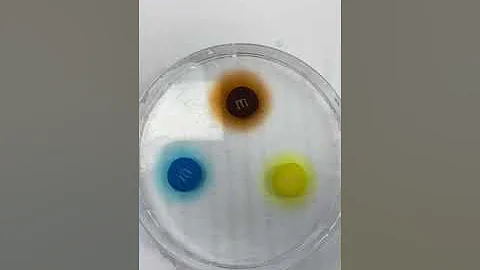

Emily A Mckernan
age ~43
from Sewell, NJ
- Also known as:
-
- Emily A Childress
- Emily Ann
- Phone and address:
-
9 Meadowview Dr, Hurffville, NJ 08080
8562457042
Emily Mckernan Phones & Addresses
- 9 Meadowview Dr, Sewell, NJ 08080 • 8562457042
- Somerdale, NJ
- Aberdeen, NC
- Fayetteville, NC
- Gloucester, NJ
Work
-
Position:Professional/Technical
Education
-
Degree:Associate degree or higher
Emails
License Records
Emily A Mckernan
Address:
Sewell, NJ 08080
License #:
TLRN026127 - Expired
Category:
Nursing
Type:
Registered Nurse Temporary Permit
Emily A Mckernan
Address:
Sewell, NJ 08080
License #:
RN586209 - Active
Category:
Nursing
Type:
Registered Nurse
Resumes

Emily Mckernan
view sourceName / Title
Company / Classification
Phones & Addresses
MACK REBAR LLC

Emily McKernan
view source
Emily Ziegler McKernan
view source
Emily McKernan
view source
Emily McKernan
view source
Emily McKernan
view source
Emily McKernan
view sourceYoutube
Myspace
Googleplus

Emily Mckernan
Get Report for Emily A Mckernan from Sewell, NJ, age ~43